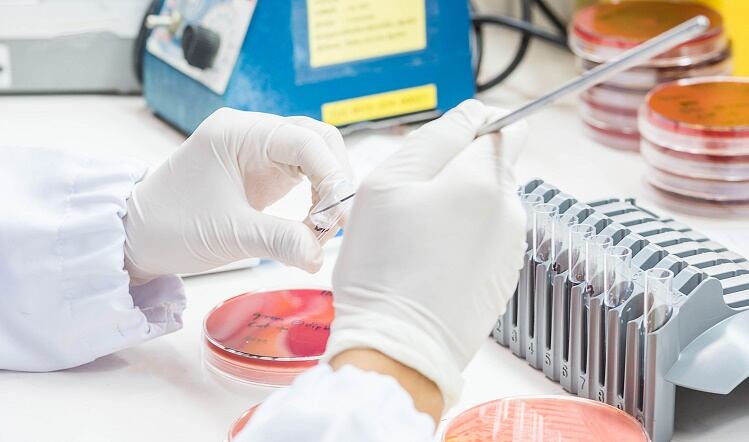

EFSA demands more data for CBD Novel Foods applications
Suppliers of cannabidiol (CBD) food products have been challenged as the European Food Standards Authority (EFSA) has refused to grant them CBD Novel Foods approval without further information.

Suppliers of cannabidiol (CBD) food products have been challenged as the European Food Standards Authority (EFSA) has refused to grant them CBD Novel Foods approval without further information.

Digital feature: long read
The past two years have brought rapid and relentless change to the food chain and this shows no signs of slackening.

Sweeping changes to legislation for nutritional information presents challenges and opportunities for food manufacturers, according to a new white paper from product development firm Griffith Foods.
The Food Standards Agency (FSA) and the Biotechnology and Biological Sciences Research Council (BBSRC) have invested £1.6m into a new UK food safety network to help better tackle food poisoning challenges.